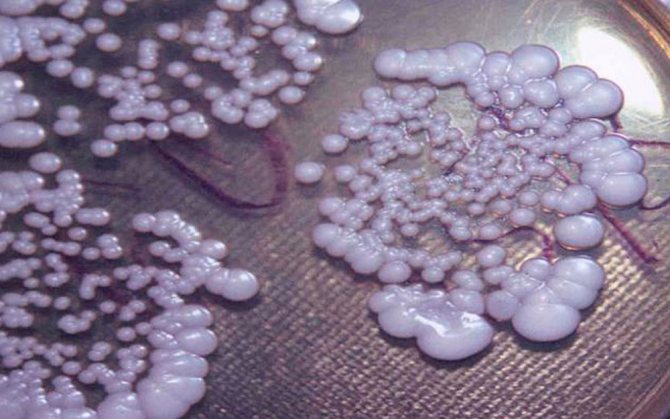

Молочница является одним из самых распространённых заболеваний женской половой сферы. Во время беременности и грудного вскармливания риск возникновения молочницы возрастает. Частое выявление данного заболевания связано с изменением гормонального фона.
Если проявления молочницы при грудном вскармливании носят выраженный характер, женщине могут быть назначены противогрибковые средства. Одним из эффективных средств против кандидоза в период грудного вскармливания является Пимафуцин.
Термин «молочница» обусловлен характерными влагалищными выделениями при заболевании. Кандидоз или молочница представляет собой грибковую инфекцию, возникающую на слизистых и кожных покровах наружных половых органов. У женщин при грудном вскармливании молочница может локализоваться на сосках.
В действительности, заболевание поражает женщин любого возрастного периода. Грибковая инфекция появляется как у новорождённых девочек, так и у пожилых женщин после наступления менопаузы. Кандидоз нередко связан с иммунными, гормональными нарушениями в организме.
Причиной молочницы являются грибы Кандида, которые относятся к условно-патогенной микрофлоре. Вместе с другими представителями нормальной флоры, например, стрептококками, стафилококками, грибы находятся на слизистых и коже. Их количество незначительно, в противном случае может развиться воспалительный процесс.
Слизистая половых органов является своеобразным механизмом защиты. В составе влагалищной микрофлоры превалирующее значение имеют лактобациллы, расщепляющие образующийся на поверхности слизистой гликоген для образования молочной кислоты. Этот компонент необходим для поддержания адекватной кислотности влагалища, не позволяющего микробам размножаться.
Когда лактобактерии объединяются в колонии, они вместе с продуктами жизнедеятельности формируют гликокаликс. Это защитная плёнка, благодаря которой патогенные микроорганизмы не могут проникнуть во влагалищную толщу.
При сокращении количества лактобацилл уровень кислотности также снижается. В результате наблюдается усиленное размножение условно-патогенной микрофлоры и возникновение воспаления. При незначительных отклонениях здоровый иммунитет справляется с временными изменениями. Однако при наличии сопутствующих патологий организм не может справиться с грибковой инфекцией.
Молочницу часто вызывают физиологические причины – беременность и грудное вскармливание. В данные периоды возникает структурная перестройка влагалищной слизистой, гормональный дисбаланс. Такие же процессы отмечаются при наступлении менопаузы.
Одной из основных причин кандидоза специалисты называют приём антибиотиков.
Острая патология протекает с выраженными проявлениями, особенно в период грудного вскармливания. Это связано с тем, что у женщин при ГВ кандидоз может поражать как слизистую влагалища, так и кожу сосков. Нехватка времени нередко приводит к игнорированию симптомов женщиной при ГВ, что со временем может вызвать переход острой формы заболевания в хроническую. Рецидивирующая хроническая форма отличается упорным течением и сложностями лечения.
Лечение кормящих
Избавиться от этого неприятного заболевания можно с помощью противогрибковых средств. Одним из самых популярных лекарств против кандидоза является пимафуцин. Он выпускается в трех формах: таблетки, крем и вагинальные свечи.
- Пимафуцин в таблетках врачи рекомендуют при таких заболеваниях, как: кандидоз слизистой рта, микоз слухового прохода, кандидоз кожи, вагинит, кандидамикоз кишечника.
- Пимафуцин в виде вагинальных свечей принимают при: вагините, вульвите, грибковых инфекциях на коже и слизистых оболочках, вызванных грибком Кандида.
- Пимафуцин-крем можно применять при таких заболеваниях, как: вульвит, вагинит, баланит, кандидоз кожи, отит грибкового происхождения.
Лечение молочницы часто носит системный характер. Если для лечения данного заболевания используются таблетки Пимафуцин, то в этот период маме лучше прекратить грудное вскармливание, так как лекарства могут ухудшить качество молока. С помощью системной терапии избавиться от кандидоза можно намного быстрее, чем при местном применении. Однако такой метод в период лактации назначается врачами очень редко.
Наиболее популярным средством для лечения молочницы при грудном вскармливании является свечи Пимафуцин. Также многие врачи рекомендуют кормящей матери бороться с этой болезнью, используя крем. Чаще всего, он применяется при легкой форме заболевания. А если кандидоз продолжает развиваться, тогда стоит переходить на свечи.
Свечи Пимафуцин, как указано в инструкции по применению, содержат антибиотик натамицин, который обладает противогрибковым действием. Он не только помогает бороться с молочницей, но и не разрушает микрофлору.
Используя свечи в борьбе с неприятным заболеванием, можно намного быстрее от него избавиться. Также они помогают быстро урегулировать работу иммунной системы.
Инструкция по применению гласит, что свечи Пимафуцин разрешено применять при грудном вскармливании, поэтому кормящей матери можно не беспокоиться о том, что этот препарат может нанести вред малышу.
Молочница – это заболевание, которое может передаваться половым путем. Поэтому лечение назначается не только женщине, но и ее партнеру.
Таблетки Пимафуцин практически не используются во время терапии вагинального кандидоза. Чаще всего, их назначают для профилактики или для восстановления микрофлоры кишечника после применения антибиотиков и кортикостероидов.
Как правильно пользоваться препаратом, и в какой дозировке, поможет инструкция. Свечи вводятся только вагинально в положении лежа. Крем применяется наружно. Если отдельно свечи и крем не справляются с грибковым заболеванием, тогда назначают таблетки Пимафуцин. Длительность лечения и дозировка определяется индивидуально врачом. Она зависит от степени тяжести болезни.
Народные методы
Помимо медикаментозного лечения молочницы во время лактации, в домашних условиях можно готовить передовика среди народных рецептов — содовые растворы для спринцевания. Candida не любит щелочную среду. На один литр кипяченой воды берется одна чайная ложка соды. Спринцевания проводятся дважды в день.
Вообще народные средства не хуже лекарственных препаратов справляются со многими заболеваниями, действуют они гораздо мягче и практически не имеют побочных эффектов (ну разве что кроме индивидуальной непереносимости). Просто эффект от лечения наступает не сразу, а через определенный промежуток времени. И конечно, такие процедуры должны быть регулярными.
Положительные свойства Пимафуцина
Очень удобным является то, что этот препарат выпускается в трех формах. Поэтому во время лечения грибковых заболеваний можно выбрать наиболее подходящее средство. Положительными свойствами этого лекарства являются:
- избавление от многочисленных разновидностей грибков;
- устранение вредных микроорганизмов;
- местное применение;
- применение при кормлении грудью, так как лекарство не всасывается в кровь и не попадает в грудное молоко;
- результат лечения можно почувствовать уже на следующий день после начала терапии;
- выбор формы лечения.
Как гласит инструкция по применению Пимафуцина, единственным противопоказанием данного препарата является индивидуальная непереносимость его отдельных компонентов. Такие моменты встречаются крайне редко, поэтому свечи, крем и таблетки Пимафуцин успешно применяются при ГВ.
Какой схемы придерживаться?
Употребление фунгистатиков внутрь при молочнице в подавляющем большинстве случаев начинается с высокой дозы – до 400 мг в первые сутки-двое с последующим переходом на дозу до 200 мг.
Смазывать отдельные участки кожи рекомендуют до 3 раз в день (народными средствами – до 5), пока не исчезнут симптомы обострения, плюс еще 4-5 дней для гарантии его гашения. Суппозитории вводят только по разу за 24 ч, на ночь, по тому же принципу (обязательно с 3-4 сутками долечивания).
Как побороть молочницу при грудном кормлении?
Молочница – это воспалительный процесс, который начинается при участии вредных грибков Кандина. Их относят к дрожжевому классу. Вредные микроорганизмы начинают активно размножаться только в том случае, если у женщины слабеет иммунитет. Однако даже у здорового человека они могут поселиться и начать активно действовать на слизистой оболочке.
Заболевание может возникнуть в период вынашивания плода и при кормлении грудью. Статистика утверждает, что недуг присутствует у 60% всех женщин.
Его сложно предотвратить, однако можно вылечить. Следует использовать только те методы, которые не смогут навредить малышу.
Заболевание в острой форме может проходить с присутствием боли и жжения в груди. При этом на сосках можно обнаружить красные пятна. Дополнительно рекомендуется присмотреться к ареоле: на ней может присутствовать блеск. Только при сильном заражении у женщины проявляются признаки сыпи с белыми пятнами. Мамочка периодически ощущает жжение и покалывание в области груди.
Еще одним симптомом молочницы считается боль, которая возникает непосредственно после окончания кормления. Заболевание приводит к нарушению продуцирования молока. Женщина должна перевести малыша на искусственный вариант кормления, если у нее была диагностирована острая форма. В противном случае можно заразить грудничка.
Кандидоз при кормлении грудью размещается не только в молочных железах. Чаще всего его можно обнаружить на слизистой оболочке влагалища. В таком случае женщина замечает сильные желтые выделения, от которых исходит неприятный запах.
При кандидозе шейка матки и влагалище могут быть травмированы, поэтому начинают кровоточить. Заболевание носит воспалительный характер и сопровождается образованием большого количества трещин. Они формируются на внутренних стенках в большом количестве и не заживают. Если лечение не начато вовремя, то кормящей маме грозит сильное воспаление яичников.
Кандидоз нуждается в своевременном лечении. В противном случае на его фоне могут появиться более серьезные патологии. После обнаружения характерных симптомов женщина должна немедленно обратиться за консультацией к лечащему врачу. В качестве основных методов терапии используют свечи или таблетки. В некоторых ситуациях решить проблему полностью сможет только комплексный подход.
Особые указания
Вагинальные капсулы при нагревании быстро растворяются, приобретая пенистую консистенцию, благодаря чему препарат равномерно и полностью покрывает внутреннюю поверхность влагалища. При хронической или рецидивирующей форме заболевания в комплексе с вагинальными суппозиториями показаны таблетки и крем Пимафуцина.
Этал, содержащийся в вагинальных капсулах, может вызывать некоторое жжение в области половых органов при непереносимости данного вещества. Во время менструаций лечение вагинальными капсулами отменяют. Во время терапии капсулами половые контакты допустимы. Вместе с тем, необходимо обследование обоих партнёров. В случае обнаружения инфекции Cand >
Пимафуцин разрешён к применению у новорождённых.
Принцип действия препарата
Пимафуцин свечи и таблетки используются не только для лечения грибковой инфекции, но также для ее предотвращения. В состав входит натамицин – главный действующий компонент, который способствует уничтожению большого количества бактерий. Вещество помогает организму побороть грибки различного рода. Даже долгое использование не вырабатывает привыкание у вредных микроорганизмов. Компонент попадает в пищеварительную систему, но растворяться начинает только в кишечнике.
Препарат доказал свою эффективность в лечении заболеваний инфекционного типа, которые формируются за счет активного распространения грибков. Ученым удалось установить, что натамицин способствует быстрому уничтожению сразу нескольких групп вредных микроорганизмов:
- кандидозное поражение слизистой оболочки влагалища или вульвы;
- активное распространение грибка в пищеварительной системе, которое происходит на фоне слабой иммунной системы;
- фиксируется сильное истощение работы всех систем организма на фоне приема отдельных групп препаратов;
- грибковое поражение носит системный характер;
- грибок активно размножается на кожном покрове и поразил ногти.
Клинические испытания
В клинических испытаниях противогрибкового средства Пимафуцин участвовали женщины с различными типами вагинитов, вызванными протистами, грибками и условно-патогенными микроорганизмами. Эффективность препарата подтвердилась во всех проведённых испытаниях. Лучшие результаты были получены в лечении вагинитов, вызванных инфекцией Candida albicans (83-95%).
Результаты испытаний показали высокую эффективность Пимафуцина в лечении рецидивирующих форм кандидозов и снижение количества грибков рода Кандида в прямой кишке после применения оральной формы препарата.
Особенности приема препарата при лактации
Пимафуцин назначается женщинам при ГВ для лечения грибковых заболеваний различного характера. Он выпускается в трех формах, каждая из которых используется при строгом наборе определенных симптомов:
- С помощью таблеток удается побороть молочницу, которая начала активно распространяться в ротовой полости, слуховом проходе. Данная форма препарата используется при поражениях кожи, наличии грибка в половых путях и кишечнике.
- Свечи помогают справиться с наружным проявлением кандидоза на половых органах. Они полностью уничтожают грибковые дрожжи, которые начали активно размножаться на слизистой оболочке.
- Крем эффективен только в случае наружного проявления грибка. Он наносится на верхние половые органы и быстро устраняет процесс воспаления. Крем прописывается для лечения грибкового поражения члена. Также помогает справиться с воспалением кожи или уха.
Для эффективного лечения Кандидоза необходимо применять системный подход. Если женщине необходимо принимать таблетки, то малыша рекомендуется перевести на искусственный вариант кормления. Данный процесс имеет ряд особенностей, с которыми женщину сможет ознакомить специалист по ГВ.
В препарат входят компоненты, которые негативно влияют на вкус молока. Системный подход позволяет быстро избавиться от симптомов болезни. Однако в период кормления рекомендуется использовать только средства с местным воздействием. В таком случае можно продолжить лактацию.
Именно поэтому в данный период лучше всего остановить свой выбор на свечах. Крем также оказывает положительное воздействие, однако в меньшей степени. Он эффективен только на первой стадии.
Свечи помогают быстро справиться с грибком и другими вредными бактериями. Кандидоз опасен, поскольку нарушает естественную микрофлору влагалища. Натамицин помогает в течение короткого времени избавиться от молочницы и укрепить иммунную систему. Свечи полностью безопасны для малыша, поскольку их компоненты не проникают в молоко матери.
Избежать побочных эффектов удастся только в том случае, если в точности следовать схеме приема. Женщине нельзя заниматься самолечением, ведь в противном случае увеличивается риск нанесения вреда здоровью малыша.
Диагностика кандидоза кишечника
- Чтобы эффективно лечить кандидомикоз кишечника, необходимо точное определения вида грибков Candida, так как разные штаммы их чувствительны к разным противогрибковым препаратам. Кроме того, необходимо определить индивидуальную чувствительность выделенных штаммов грибков к антимикотическим препаратам.
- Наиболее достоверным методом диагностики кандидоза является обнаружение грибка при исследовании жидкостей и тканей организма, которые в норме должны быть стерильными (например, в синовиальной жидкости из полости суставов, в тканях кишечника при их биопсии и т. д.)
- Серологические исследования, с помощью которых определяется уровень содержания в сыворотке крови антител к грибкам. Но оценивать полученные данные должен только врач, так как даже положительный результат может быть признаком носительства у лиц, когда-то переболевших кандидозом или с ослабленным иммунитетом.
- Бактериологическое исследование кала позволяет установить, есть ли в организме человека патогенные бактерии (возбудители кишечных инфекций). В норме число грибов рода Candida не должно превышать более 10³ КОЕ/г.
- Фиброколоноскопия позволяет визуально оценить состояние кишечника, провести биопсию для микроскопического исследования. При помощи эндоскопа можно собрать кал из разных участков кишечника, чтобы провести более точный анализ состава микрофлоры.
Формы заболевания
Сегодня описываемый недуг встречается в 2-х формах. Это зависит от механизмов его формирования.
Кишечный кандидоз бывает:
- Инвазивным, когда отмечается проникновение грибка дрожжеподобной природы в каждую клетку кишечника. – Инвазивная форма в свою очередь бывает очаговой, фокальной и диффузной.
- Не инвазивным, когда происходит значительное увеличение численности инфекции исключительно в кишечном просвете.
Для того чтобы правильно ответить на вопрос, как лечить кандидоз кишечника, необходимо верно диагностировать его форму.
Отзывы
Екатерина, 28 лет, Иркутск
На 5-м месяце беременности у меня обострился кандидоз (хотя до этого уже 2 года не обострялся). Поела сладостей – и буквально на следующий день появились знакомые симптомы. Видимо беременность сыграла решающую роль, всё-таки гормональный фон изменился. Гинеколог назначила вагинальные суппозитории, которые беременным применять нельзя, поэтому пришлось самой искать нормальное средство. На медицинском сайте почитала про Пимафуцин. Один из немногих препаратов в форме вагинальных суппозиториев, который не противопоказан при беременности. В упаковке – по 3 и 6 капсул. Приобрела упаковку с тремя капсулами – она мне обошлась в 300 руб. Использовала, согласно инструкции, перед сном. Капсулы мягкие и очень непрочные, поэтому вытаскивать их нужно аккуратно, иначе могут лопнуть в руках. Весь следующий день содержимое капсул вытекало, что создало немало дискомфорта – пришлось поменять три ежедневки. Зато к вечеру уже почувствовала облегчение – зуд и жжение пропали. Ну я решила закрепить эффект, и использовала две оставшиеся капсулы – пришлось помучаться два дня. В итоге помог – симптомы так и не возобновились, и после родов всё было в порядке. Но от сладостей я тогда решила всё-таки воздержаться. Препарат хороший, рекомендую всем.
Анна, 36 лет, Москва
Пимафуцин уже не один раз спасал меня во время беременности. Средство совершенно безвредное, побочного действия не имеет. Капсулы вводятся просто и без проблем – никаких болей не возникает. Пожалуй, это один из немногих препаратов, которые можно смело использовать без назначения врача, не рискуя ни собственным здоровьем, ни здоровьем ребёнка. Правда есть одна особенность – при беременности Пимафуцин спасает лишь на определённый промежуток времени, т.к. микробиоценоз влагалища нормализуется только после родов (по крайней мере у меня так было). В любом случае, это лучший препарат, что я пробовала. Поэтому советую попробовать, и не пугайтесь цены – он того стоит.
Светлана, 32 года, Харьков
Пимафуцин я купила после того, как у меня обострился кандидоз после лечения вагинальными капсулами Вагинорм-С. Стоит он, конечно, немало, но я все-таки решила купить. Тогда я решила не разводить самодеятельность, и следовать рекомендациям своего гинеколога, поэтому купила пачку с 6-ю свечами. Пришлось выложить за это 500 руб. Капсулы плотные, и в руках не растекаются, как часто бывает. Вводила их 6 дней, по одной в день перед сном. Побочных эффектов, слава богу, не было. Правда во время лечения лекарство постоянно вытекало, приходилось менять по несколько прокладок. Но это, пожалуй, единственный минус. Симптомы стали сходить на нет уже на второй день, а к 6-му дню от них и следа не осталось. Через неделю после окончания курса сдала мазок – всё чисто, никакой инфекции. Поэтому могу с уверенностью утверждать – препарат замечательный, попробуйте – не пожалеете.
Автор: Сорокачук К.Г. Координатор проекта по контенту.
Практически всем известно, что кандидоз
или
молочница
— это не просто инфекционное заболевание, а очень часто признак ослабленного иммунитета, ведь очень часто оно возникает на фоне приема антибиотиков, при серьезных, ослабляющих защитные силы организма заболеваниях. Поэтому, безусловно, обязательным этапом в борьбе с молочницей является укрепление собственного иммунитета, однако в большинстве случаев этого недостаточно, требуется прием противогрибковых препаратов. И здесь многие встают перед выбором «того самого» препарата, который на сегодня достаточно широк. Есть среди этих лекарств широко разрекламированные средства, но будет ли от них польза? Мы поговорим о пимафуцине: его эффективности, отзывах и возможных недостатках.
Факторы риска для возникновения грибков Candida
Среди общих факторов, предварительно располагающих кишечник к появлению кандидоза, следует выделить:
- Низкую иммунную защиту.
- Несбалансированный приём пищи.
- Активную, продолжительную терапию антибактериальными препаратами, которая приводит к угнетению полезной микрофлоры кишечника с одновременным избыточным размножением Candida.
Распространение грибков по всему организму